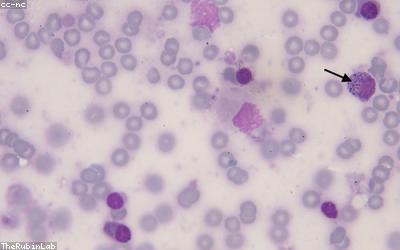

Microbiology
The deeper you look into microbiology, the stranger and more fascinating it becomes.
At a Glance
- Subject: Microbiology
- Category: Biology

Microbes: The Invisible Masters of Our World
When you look around, the world may seem dominated by the visible creatures we can see with the naked eye – the plants, animals, and fungi that make up the macroscopic life we're familiar with. But lurking beneath the surface, in every nook and cranny, is an entire unseen universe teeming with life. Microbes, the microscopic organisms that make up the foundation of all life on Earth, are the true masters of our world.

The Remarkable Diversity of Microbial Life
Microbes come in a dizzying array of shapes, sizes, and capabilities. Bacteria, the most numerous and diverse group, can be found in virtually every environment on Earth – from boiling hot springs to the frozen Antarctic, from deep underground to the upper atmosphere. Archaea, an ancient domain of single-celled organisms, thrive in some of the planet's most extreme conditions. Viruses, the smallest and most abundant biological entities, infect every type of living organism and play a crucial role in shaping the microbial world. Eukaryotic microbes like protists and fungi, though less numerous than bacteria and archaea, exhibit a remarkable degree of complexity and diversity.
"The world of the very small, inhabited by microbes, is more mysterious than the visible world." - Lewis Thomas, biologist and essayist



Microbes and Human Health
Microbes don't just inhabit the natural world – they're also intimately connected to the human body. The human microbiome, the trillions of microbes that live on and within us, play a crucial role in our health and well-being. These microbial residents help digest our food, produce essential vitamins, train our immune systems, and even influence our moods and behaviors. While some microbes can cause diseases, the vast majority are either harmless or even beneficial.

The Unseen Drivers of Ecosystems
Beyond the human body, microbes are the hidden engines that power the natural world. They drive the global cycles of carbon, nitrogen, and other essential elements, transforming dead organic matter into the building blocks of life. Microbes form the base of nearly every food chain, providing nourishment for larger organisms. They can even influence the climate, with certain types of microbes helping to seed clouds and regulate temperature.
The Microbial Frontier
Despite their ubiquity and importance, microbes remain one of the final frontiers of human knowledge. We've only begun to scratch the surface of microbial diversity, with estimates suggesting that over 99% of microbial species remain undiscovered. As our technologies for studying the microscopic world continue to advance, the secrets of these invisible masters are slowly being revealed – opening up new realms of scientific understanding and potential applications in fields ranging from medicine to energy production to environmental restoration.
Comments